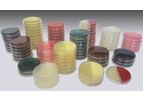
Innovatek - Dalynn Media and Reagents

- Home
- Companies
- canada british columbia
- environmental monitoring
Refine by
Industries served
- Monitoring and Testing
- Agriculture
- Soil and Groundwater
- Environmental
- Air and Climate
- Food and Beverage
- Energy
- Mining
- Oil, Gas & Refineries
- Water and Wastewater
- Health and Safety
- Medical / Health Care
- Chemical & Pharmaceuticals
- Pulp & Paper
- Waste and Recycling
- University / Academia / Research
- Forestry & Wood
- Glassware
- Manufacturing, Other
- Construction & Construction Materials
Environmental Monitoring Suppliers In Canada British Columbia
7 companies found

Premium
based inJena, GERMANY
Analytik Jena is a leading provider of high-end analytical measuring technology, instruments, and products in the fields of biotechnology and molecular diagnostics and high quality liquid handling and automation technologies. ...

Premium
based inBurwell, UNITED KINGDOM
Delta-T offers a wide range of data loggers and sensors able to measure and record hydrological, meteorological and other environmental parameters. Our products provide direct measurements of the forces and effects that renewable energy and other ...

Premium
based inMission, BRITISH COLUMBIA (CANADA)
For more than 30 years, Lumex Instruments has been developing and manufacturing laboratory and industrial analytical equipment, instruments, and procedures. Our products are used for environmental control, water and wastewater treatment, ...

based inPullman, WASHINGTON (USA)
METER Group delivers real-time, high-resolution environmental data that fuels production and processes for the food quality, environmental research, urban and agriculture sectors. Through the power of its employees, METER combines science, ...
based inCalgary, ALBERTA (CANADA)
HSE Integrated Ltd. is Canada’s largest national industrial safety services company with operations across the country and into the United States. The first of its type, HSE provides a comprehensive and integrated suite of health, safety and ...

based inDelta, BRITISH COLUMBIA (CANADA)
Innovatek Medical Inc. is a manufacturer, importer and distributor of medical devices, founded in 1990. We're a Canadian company providing rapid diagnostic kits in the areas of women's health, drugs of abuse, and infectious diseases. We also supply ...
We offer a full range of culture media, CHROMagar plates, and Pre-Reduced Anaerobically Sterilized Media. Plated media is available in variety of formats including mono-plates, bi-plates, contact plates and 60 mm plates for filtration ...

based inNew York, NEW YORK (USA)
Bureau Veritas is a recognized world leader in testing, inspection and certification services (TIC). Our mission is at the heart of key challenges: quality, health and safety, environmental protection and social responsibility. Through our wide ...